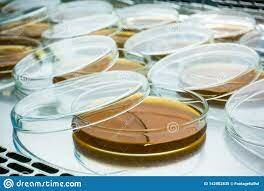
Cajas Petri

Historia de la Microbiología Aplicada para la maestra Angelica Villaruel
-
 En 1658, A. Kirchner, Advirtió cuál era el papel de los microorganismos en la alteración de los alimentos al verlos en descomposición.
En 1658, A. Kirchner, Advirtió cuál era el papel de los microorganismos en la alteración de los alimentos al verlos en descomposición. -
 En 1665, Robert Hooke descubrió la célula.
En 1665, Robert Hooke descubrió la célula. -
 La primera persona en describir los microorganismos en detalle fue el holandés Antony van Leeuwenhoek en 1684.
La primera persona en describir los microorganismos en detalle fue el holandés Antony van Leeuwenhoek en 1684. -
 Edward jenner un medico, investigador y poeta descubrió la primer vacuna
Edward jenner un medico, investigador y poeta descubrió la primer vacuna -
 Francois Nicolas Appert
Francois Nicolas Appert
Desarrolló métodos para conservar alimentos en vidrio sellado botellas por calor en agua hirviendo -
 Los químicos alemanes von Liebig y Wöhler tenían teorías que reconocían la presencia de levaduras en la fermentación alcohólica, pero estas levaduras eran consideradas como compuestos químicos complejos, sin vida
Los químicos alemanes von Liebig y Wöhler tenían teorías que reconocían la presencia de levaduras en la fermentación alcohólica, pero estas levaduras eran consideradas como compuestos químicos complejos, sin vida -
 Los químicos alemanes von Liebig y Wöhler tenían teorías que reconocían la presencia de levaduras en la fermentación alcohólica, pero estas levaduras eran consideradas como compuestos químicos complejos, sin vida
Los químicos alemanes von Liebig y Wöhler tenían teorías que reconocían la presencia de levaduras en la fermentación alcohólica, pero estas levaduras eran consideradas como compuestos químicos complejos, sin vida -
 Von Hessling, en 1866, afirmó que las diversas fermentaciones de la leche, así como la maduración de los quesos, eran causadas por hongos, y muchas otras investigaciones que derivaron en nuevas técnicas de conservación más efectivas y duraderas, como la refrigeración y congelación y tantas otras que hoy conocemos
Von Hessling, en 1866, afirmó que las diversas fermentaciones de la leche, así como la maduración de los quesos, eran causadas por hongos, y muchas otras investigaciones que derivaron en nuevas técnicas de conservación más efectivas y duraderas, como la refrigeración y congelación y tantas otras que hoy conocemos -
 En 1880 Pasteur utilizó las técnicas de Koch para aislar y cultivar la bacteria que causa el cólera en gallinas
En 1880 Pasteur utilizó las técnicas de Koch para aislar y cultivar la bacteria que causa el cólera en gallinas -
Richard Petri introduce el uso de las placas Petri en Microbiología.
Richard Petri introduce el uso de las placas Petri en Microbiología. -
 En 1895 Harry Russell Demostró que la hinchazón gaseosa con los malos olores en los guisantes en lata era debido al crecimiento de las bacterias resistentes al calor (esporas)
En 1895 Harry Russell Demostró que la hinchazón gaseosa con los malos olores en los guisantes en lata era debido al crecimiento de las bacterias resistentes al calor (esporas) -
 Martinus Beijerinck hizo dos grandes contribuciones a la microbiología: el descubrimiento de los virus y el desarrollo de técnicas de cultivo microbiológico.
Martinus Beijerinck hizo dos grandes contribuciones a la microbiología: el descubrimiento de los virus y el desarrollo de técnicas de cultivo microbiológico. -
 El enlatado desarrollado en el siglo XIX terminó con las técnicas tradicionales de conservación de carnes como el salado, el ahumado, sino también ablandar sistemático de la carne de venado.
El enlatado desarrollado en el siglo XIX terminó con las técnicas tradicionales de conservación de carnes como el salado, el ahumado, sino también ablandar sistemático de la carne de venado. -
 En 1928 el microbiólogo inglés Alexander Fleming observó que en una placa de agar inoculada con Staphylococcus aureus que estaba contaminada con el hongo Penicillium notatum, las colonias de Staphylococcus eran destruídas por alguna actividad de las colonias del hongo. A partir de este hongo realizó la extracción de un compuesto que era el responsable del efecto inhibitorio al que llamó Penicilina
En 1928 el microbiólogo inglés Alexander Fleming observó que en una placa de agar inoculada con Staphylococcus aureus que estaba contaminada con el hongo Penicillium notatum, las colonias de Staphylococcus eran destruídas por alguna actividad de las colonias del hongo. A partir de este hongo realizó la extracción de un compuesto que era el responsable del efecto inhibitorio al que llamó Penicilina -
 En 1944 Oswald Avery, Colin MacLeod y MacLyn McCarty descubrieron el papel del DNA en la genética bacterian
En 1944 Oswald Avery, Colin MacLeod y MacLyn McCarty descubrieron el papel del DNA en la genética bacterian -
 Fue considerado como una ciencia aplicada principalmente involucrados en el control de la calidad microbiológica de los alimentos
Fue considerado como una ciencia aplicada principalmente involucrados en el control de la calidad microbiológica de los alimentos -
 La ingeniería genética es la tecnología del control y transferencia de ADN de un organismo a otro, lo que posibilita la corrección de los defectos genéticos y la creación de nuevas cepas (microorganismos), variedades (plantas) y razas (animales) para una obtención más eficiente de sus productos
La ingeniería genética es la tecnología del control y transferencia de ADN de un organismo a otro, lo que posibilita la corrección de los defectos genéticos y la creación de nuevas cepas (microorganismos), variedades (plantas) y razas (animales) para una obtención más eficiente de sus productos -
 La viruela fue declarada oficialmente erradicada en 1980, y es la primera enfermedad combatida a escala mundial. Este éxito extraordinario se logró gracias a la colaboración de países de todo el mundo
La viruela fue declarada oficialmente erradicada en 1980, y es la primera enfermedad combatida a escala mundial. Este éxito extraordinario se logró gracias a la colaboración de países de todo el mundo -
La mayoría de las cepas de H. influenzae son patógenos oportunista, estos tipos de patógenos viven en su huésped sin causar enfermedades,pero pueden causar problemas cuando otros factores crean una oportunidad infecciosa
-
 se secuencia el genoma del saccharopolyspora erythraea el microorganismo productor del antibiótico eritromicina
se secuencia el genoma del saccharopolyspora erythraea el microorganismo productor del antibiótico eritromicina -
 El influenzavirus A subtipo H1N1, mejor conocido como gripe A H1N1 humana o indistintamente A N1H1 humana , es un subtipo de influenzavirus tipo A del virus de la gripe, perteneciente a la familia de los Orthomyxoviridae.El H1N1 ha mutado en diversos subtipos que incluyen la gripe española (extinta en la vida silvestre), la gripe porcina, la gripe aviar y la gripe bovina. La cepa mantiene su circulación después de haber sido reintroducida por la población humana en los años 1970.
El influenzavirus A subtipo H1N1, mejor conocido como gripe A H1N1 humana o indistintamente A N1H1 humana , es un subtipo de influenzavirus tipo A del virus de la gripe, perteneciente a la familia de los Orthomyxoviridae.El H1N1 ha mutado en diversos subtipos que incluyen la gripe española (extinta en la vida silvestre), la gripe porcina, la gripe aviar y la gripe bovina. La cepa mantiene su circulación después de haber sido reintroducida por la población humana en los años 1970. -
 Se descubre el proceso de esporulación en Mycobacterium
Se descubre el proceso de esporulación en Mycobacterium -
 Virus que causa una enfermedad respiratoria llamada enfermedad por coronavirus de 2019 (COVID-19). El SARS-CoV-2 es un virus de la gran familia de los coronavirus, un tipo de virus que infecta a seres humanos y algunos animales.
Virus que causa una enfermedad respiratoria llamada enfermedad por coronavirus de 2019 (COVID-19). El SARS-CoV-2 es un virus de la gran familia de los coronavirus, un tipo de virus que infecta a seres humanos y algunos animales. -
A list shows items. A timeline shows sequence.
Use Timetoast to make dates, milestones, and turning points easier to understand in a clear visual format. Timetoast is a timeline maker for work, school, research, and stories.
